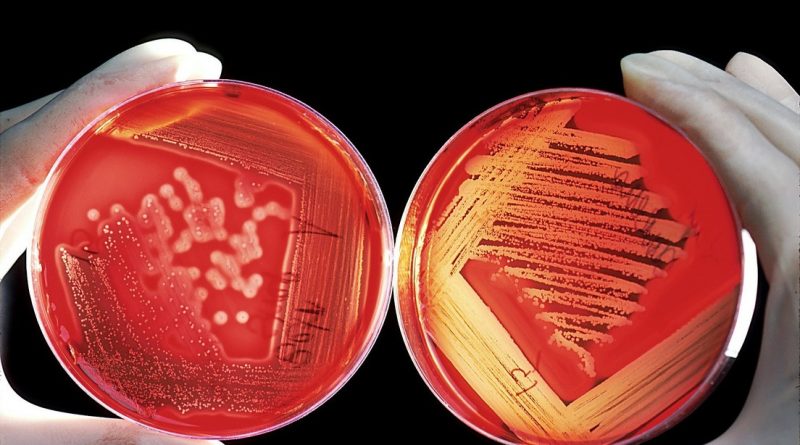

Descubren en las profundidades marinas bacterias que son “indetectables” para el sistema inmunológico humano
En su más reciente estudio, un equipo internacional de científicos descubrió en las profundidades del océano Pacífico un grupo de bacterias que son “indetectables” para el sistema inmunológico humano, hallazgo que podría arrojar nueva luz sobre la respuesta de nuestros organismos ante la presencia de agentes patógenos desconocidos.
Con el fin de comprobar la hipótesis que sugiere que las células inmunológicas son capaces de detectar cualquier agente extraño que ingrese al cuerpo humano, los investigadores recolectaron bacterias cerca de las costas de las Islas Phoenix, un área protegida de Kiribati, territorio insular ubicado en una de las zonas más remotas del océano Pacífico.
Mediante un submarino operado a control remoto a 4.000 metros de profundidad, los académicos recolectaron muestras de agua, de esponjas y estrellas marinas, así como del sedimento, de las cuales lograron extraer y cultivar en laboratorio un total de 117 especies distintas de bacterias.
Una vez identificadas las características de los microbios, seleccionaron 50 tipos distintos para medir la respuesta inmunitaria de ratones y humanos.
Los resultados de las pruebas, publicados recientemente en la revista Science Immunology, indicaron que 80 % de esos microrganismos, la mayoría del género ‘Moritella’, resultaron “invisibles” e “indetectables” para las células especializadas del sistema inmune.
Esta “sorprendente” ‘invisibilidad’, explicó Jonathan Kagan, coautor de la publicación, se debe a que las cadenas de lípidos de las moléculas de lipopolisacáridos de la pared celular de esas bacterias, que son usadas por las células inmunitarias de los mamíferos para identificar a los patógenos, son considerablemente más largas que las halladas en las bacterias terrestres.
Los resultados obtenidos, concluyen los investigadores, ponen de manifiesto la probable respuesta del sistema inmunológico ante microbios exóticos, por lo que esperan que su estudio contribuya en gran medida a desarrollar inmunoterapias que sean más efectivas. (RT)